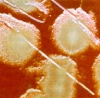
Антибиотики перестают помогать

отметили
82
человека
в архиве
На Втором Всемирном интернет-форуме Россия будет требовать передать контроль над Интернетом от США к ООН
 rbcdaily.ru
rbcdaily.ru
На передаче оперативного управления Всемирной паутиной от частной американской компании ICCAN в руки международной общественности настаивает Россия. Именно об этом делегация РФ собирается говорить на Втором всемирном форуме по вопросам управления Интернетом, открывшемся вчера в Рио-де-Жанейро. По мн...
24 комментария
проблема (1)
отметили
11
человек
в архиве
Одним из главных музыкальных критиков Amazon оказался безработный без доступа в Сеть
 lenta.ru
lenta.ru
Британское издание The Telegraph назвало имя одного из самых активных рецензентов крупнейшего онлайн-магазина Amazon. Автором более 5000 рецензий, которые понравились 50 тысячам посетителей Amazon, оказался пятидесятишестилетний безработный Питер Харрис, у которого дома нет ни телевизора, ни доступа...
проблема (1)
отметили
56
человек
в архиве
Сегодня в Ингушетии, завтра в Москве? Руководство Ингушетии ввело ограничения на доступ к интернет-сайтам habrahabr.ru
12 ноября директор ООО "Телеком" Ибрагим Албаков и его программист Илес Дзауров были вызваны к министру внутренних дел РИ Мусе Медову. В кабинете у Медова находились директор ФГУП "РТРС" (радиотелевизионный передающий центр) Алик Бузуртанов и бывший руководитель Россвязьнадзора п...
проблема (1)
отметили
24
человека
в архиве
15555 новость на news2.ru
 news2.ru
news2.ru
Поздравляю администрацию и читателей с круглой цифрой. :)
проблема (16)
отметили
6
человек
в архиве
У гиперактивных детей мозг развивается медленней
 medportal.ru
medportal.ru
Различия между здоровыми детьми и детьми, страдающими синдромом дефицита внимания с гиперактивностью (СДВГ), могут объясняться особенностями развития коры головного мозга, полагают американские ученые. При СДВГ мозговые центры, отвечающие за внимание и планирование, созревают на три года позже, сооб...
проблема (1)
отметили
28
человек
в архиве
74-летний голландец всю жизнь водил машину без прав
 korrespondent.net
korrespondent.net
Голландская полиция задержала 74-летнего жителя города Энсехеде, который, как выяснилось, 55 лет водил машину без водительского удостоверения.
Как сообщает голландское радио, полицейские остановили мужчину впервые за полвека, поскольку он ехал, не пристегнувшись ремнем безопасности.
...
отметили
2
человека
в архиве
Самые дерзкие аферы
 bishelp.ru
bishelp.ru
В 2006 году, по статистике, в ходе финансовых махинаций 28 млн британцев лишились 1 млрд фунтов. Обозреватели The Times составили рейтинг самых дерзких афер. Многим россиянам истории о типичных случаях обмана покажутся "до боли" знакомыми…
отметили
3
человека
в архиве
Запрещена регистрация IDN доменов в com.ua domainblog.com.ua
Совсем недавно еще можно было регистрировать IDN домены в зоне com.ua.
IDN (это интернациональные, международные) доменные имена такого вида как интернет.com.ua.
Это означает, что при наборе таких доменов нужно часть букв набирать на русском и часть на английском языке.
Основна...
отметили
45
человек
в архиве
В Великобритании массово увольняют сотрудников, которые используют интернет в личных целях
 hitech.newsru.com
hitech.newsru.com
Почти две тысячи сотрудников британских государственных компаний были уволены или получили взыскания за использование интернета в личных целях во время рабочего дня, сообщает ИТАР-ТАСС со ссылкой на The Daily Telegraph.
С распространением электронной почты и сайтов для социального общения, ...
отметили
30
человек
в архиве
Свадебный кортеж из … троллейбусов
 yuzle.com
yuzle.com
Белорусским молодожёнам, видимо, уже не в «кайф» арендовать свадебные лимузины или «рассекать» по городу на украшенных «лупатых» «Мерсах» или агрессивных «Бумерах». Теперь они начали использовать в кортеже троллейбусы.
отметили
24
человека
в архиве
Microsoft пытается составить конкуренцию связке iPhone и iTunes
 telnews.ru
telnews.ru
Microsoft планирует приобретение музыкального мобильного сервис-провайдера Musiwave, поскольку готовится сделать новые предложения своим клиентам в мобильной сфере. Musiwave предоставляет мобильным операторам широкий выбор музыкальных сервисов, включая полные версии популярных композиций, рингтоны и...
отметили
5
человек
в архиве
отметили
36
человек
в архиве
Новый торрент-гигант SUMOtorrent
 rublicon.ru
rublicon.ru
Сравнительно новый торрент-сайт SUMOtorrent спустя всего несколько месяцев с момента своего появления уже привлекает порядка 350 тыс. уникальных посетителей ежедневно, что делает его одним из самых посещаемых проектов в своем роде. К концу прошлой недели SUMOtorrent добрался до 1052-ой строчки в рей...
отметили
34
человека
в архиве
Сеть по электропроводке: 400 Мбит/с в начале следующего года
 ixbt.com
ixbt.com
Компания Comtrend, специализирующаяся на производстве сетевого оборудования, в начале следующего года планирует начать продажу адаптеров, позволяющих подключаться к сетям Ethernet по электропроводке. При этом компания заявляет, что их новые адаптеры в идеале позволят достигать скорости передачи данн...
проблема (2)
отметили
50
человек
в архиве
Глава Генштаба РФ сделал США предупреждение
 rambler.ru
rambler.ru
В руководстве России продолжают расценивать элементы ПРО, которые США хочет разместить в Восточной Европе, как угрозу безопасности страны. Об этом российскому англоязычному спутниковому телеканалу "Russia Today" заявил начальник Генерального штаба Вооруженных Сил РФ генерал армии Юрий Балу...
проблема (1)
отметили
46
человек
в архиве
IMhоnet – сеть советов в мире кино и книг
 internetno.net
internetno.net
Проект под названием “Ваш персональный рекомендатор” берет на себя задачу порекомендовать пользователям интересные для него лично книги и фильмы. Причем делает это сервис автоматически – пользователю не нужно просматривать кучу страниц и читать длинные рецензии – все это работает гораздо проще.
проблема (1)
отметили
8
человек
в архиве
Вредные свойства вина medblog.ru
Несколько дней назад я писал о полезных свойствах вина… Но вино может быть полезно не всем. Если у человека есть некоторые заболевания, то вино может лишь усугубить его положение. Поэтому крайне важно посоветоваться с врачом, прежде чем регулярно употреблять вино. Кстати, качество вина тоже весьма в...
проблема (2)
отметили
4
человека
в архиве
Рост зарплат превышает рост производительности труда
 news.ntv.ru
news.ntv.ru
Исследование, проведённое кадровым холдингом «Анкор» показало, что в России зарплаты растут быстрее производительности труда и инфляции. Больше всего за год «подорожали» ИТ-специалисты и менеджеры по продажам, меньше всего — топ-менеджеры.
отметили
6
человек
в архиве
отметили
4
человека
в архиве
Официальный сайт британской разведслужбы MI-5 теперь доступен и на русском языке
 britanets.com
britanets.com
По всей видимости, шпионская угроза со стороны России и Китая оказалась настолько значительной, что MI-5 приняла решение о создании русской и китайской версий своего официального веб-сайта.
проблема (4)
отметили
4
человека
в архиве
Производители программ будут покупать лицензии для тиражирования своих продуктов
 webplanet.ru
webplanet.ru
Правительство одобрило и внесло в Госдуму законопроект, согласно которому производителей программ обяжут получать лицензии на тиражирование своей продукции. По задумке законотворцев эта мера должна сократить количество пиратского ПО в нашей стране. Однако при создании закона не учли, что основной ка...
отметили
29
человек
в архиве
Путин: "Единая Россия" не идеальна, но она близка к власти. Многие "хотят примазаться к ней"
 newsru.com
newsru.com
"Единая Россия" сегодня должна стать гарантом власти, к чему она и приближается. "Там нет пока устойчивой идеологии, принципов, за которые подавляющее большинство членов этой партии готовы бороться и положить свой авторитет. Но тем не менее она близка к власти. А к таким структурам, к...
проблема (2)
отметили
24
человека
в архиве
Страховщики хотят повысить тарифы Автогражданки минимум на 20%
 top.rbc.ru
top.rbc.ru
Страховщики намерены повысить тарифы по ОСАГО минимум на 20%. В противном случае, по их словам, рынок "автогражданки" может "обанкротиться" уже в 2008 году. Об этом, как пишет газета РБК daily, было накануне заявлено на конференции "ОСАГО: тарификация и регулирование".
отметили
5
человек
в архиве
отметили
13
человека
в архиве
Создана компьютерная модель фотосинтеза
 membrana.ru
membrana.ru
Компьютерная модель учёных имитирует все этапы процесса фотосинтеза. И хотя исследователи потратили на её создание уйму времени и средств, такой результат получить значительно легче и дешевле, чем если бы пришлось изучать влияние каждого белка в отдельности в реальном листе.
Если считать, что эв...
отметили
71
человек
в архиве
46 лучших кнопок/иконок RSS
 uniqman.com
uniqman.com
Подборка интересных RSS иконок для блогов и сайтов: большие и маленькие, объемные и плоские, оранжевые и желтые.
проблема (5)
отметили
15
человек
в архиве
У статуи Джона Леннона в Ливерпуле украли очки
 top.rbc.ru
top.rbc.ru
Джон Леннон подвергся нападению со стороны охотника за сувенирами. Пострадал, естественно, не сам легендарный певец, погибший 27 лет назад, а его статуя в аэропорту имени Джона Леннона в Ливерпуле, с которой неизвестный фанат творчества музыканта отодрал очки.
отметили
10
человек
в архиве
Харьковскую улицу назовут именем поисковика Meta.ua
 webplanet.ru
webplanet.ru
Более тысячи жителей города Харькова поставили свои подписи под предложением переименовать главную улицу города — Сумскую — в проспект имени Meta.ua, популярной на Украине поисковой системы.
проблема (1)
отметили
25
человек
в архиве
На русском языке, с любовью от MI-5 сайт для информаторов-контрразведчиков
 inopressa.ru
inopressa.ru
Шпионская угроза для Великобритании, исходящая из Москвы и Пекина, считается настолько значительной, что MI-5 перевела свои сайты в интернете на русский и китайский языки с целью вербовки информаторов.
Ранее существовали версии сайта на английском и валлийском (как того требует закон), а та...
проблема (1)
отметили
60
человек
в архиве
Антибиотики перестают помогать
 vokrugsveta.ru
vokrugsveta.ru
Бактерии все чаще устойчивы к лекарствам, и врачи уже совсем скоро ждут роста смертности…
проблема (1)